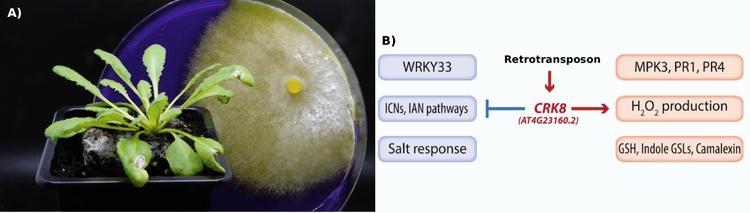
January 2026 TPJ Editor choice.jpg

January 2026 TPJ Editor choice: Transposon toggle: Flipping the switch on CRK8 expression for pathogen defense
https://doi.org/10.1111/tpj.70590
Transposon toggle: Flipping the switch on CRK8 expression for pathogen defense
The necrotrophic fungus Sclerotinia sclerotiorum has a huge host range: sunflowers, canola, beans, soybeans, lettuce, and many ornamentals. In a severe epidemic year, soybean losses in the United States attributed to S. sclerotiorum stem rot have been estimated at 560 million USD.
Plant genes that confer complete resistance to S. sclerotiorum have not been identified. Instead, plant populations challenged by S. sclerotiorum display a continuum of partial resistance collectively known as quantitative disease resistance (QDR). Because QDR typically involves multiple genes, it often provides durable and broad-spectrum protection, making it valuable for sustainable crop protection strategies. Macquet et al. applied a genome-wide association mapping approach in 84 European Arabidopsis accessions to identify loci associated with resistance to S. sclerotiorum. Among the SNPs with the highest association score was one upstream of the Cysteine-Rich Receptor-like Kinase 8 (CRK8) gene. CRKs are membrane-bound receptors with extracellular cysteine-rich domains that play roles in plant immunity. In Columbia-0, the SNP was located within a retrotransposon, which spans 2.1 Kbp upstream of CRK8.
Pathogen infection often triggers CRK transcription. In both healthy and inoculated plants, CRK8 was expressed around five times higher in accessions with the retrotransposon than in accessions lacking this transposable element, suggesting that the transposon regulates CRK8 expression independent of pathogen infection. Overall, fewer disease symptoms occurred in accessions with a higher-than-average CRK8 expression, suggesting that increased expression is correlated with resistance.
To clarify the function of CRK8, the authors analysed two mutant lines: the activation-tagging line crk8.1, which overexpresses CRK8 in healthy plants but shows reduced CRK8 expression after pathogen inoculation, and the knock-down line crk8.3, with a reduced expression in both conditions. The crk8.3 plants displayed faster lesion formation, indicating impaired disease resistance. The expression level of several well-known defense-related marker genes in the mutants likely reflected the opposite alterations of CRK8 expression in healthy crk8.1 and crk8.3 plants.
Reactive oxygen species (ROS) are important signalling molecules in plant defense, and CRKs regulate ROS production in response to pathogens. Consistent with this, CRK8 positively regulated the pathogenesis-related genes PR1 and PR4 and promoted ROS production through the negative regulation of the gene encoding alternative oxidase 1D.
To investigate the transcriptional changes underlying the pathogen response, the authors analysed the transcriptome of crk8 mutants under both healthy and S. sclerotiorum-infected conditions. The transcriptomes of crk8.1 and crk8.3 mutants were highly similar. Interestingly, CRK8 seemed to exert opposing effects at different stages of the immune response. The authors speculate that CRK8 activity might preferentially activate certain defense pathways while suppressing others, creating specificity in the immune output.
Production of the secondary metabolite camalexin contributes to defense against S. sclerotiorum. In the transcriptome data, CRK8-dependent genes related to camalexin biosynthesis were significantly more highly expressed upon S. sclerotiorum inoculation. Additionally, camalexin production in both crk8 mutants was lower than in the wild type after infection, suggesting that camalexin production in response to S. sclerotiorum can be regulated by CRK8.
In addition to defense-related genes, salt stress-related genes were also more highly expressed. Salt exposure strongly inhibited germination in wild type. This effect was more pronounced in crk8.1, whereas crk8.3 showed comparatively higher germination. Notably, elevated CRK8 expression in crk8.1 was associated with delayed germination, suggesting that low CRK8 expression correlates with improved germination under salt stress.
In summary, a single transposon insertion upstream of CRK8 increased its expression, enhancing disease resistance but reducing germination on high salt in natural accessions, thereby shifting a CRK8-mediated stress-response trade-off. The transposon upstream of CRK8 likely carries its own regulatory sequences that allowed it to introduce novel regulatory logic to existing genes with a single insertion event.
Figure 1: The retrotransposon upstream of CRK8 regulates a CRK8-dependent trade-off between defense response to Sclerotinia sclerotiorum and salt tolerance.
A) Arabidopsis plant inoculated with S. sclerotiorum in front S. sclerotiorum growing on a petri dish with a medium containing bromo-phenol blue. Image credit: Mehdi Khafif, INRAE.
B) The retrotransposon positively affects CRK8 expression, which then negatively affects salt-related responses. At the same time, CRK8 positively affects defense-related pathways (right). Figure modified from (Macquet et al., 2025).
